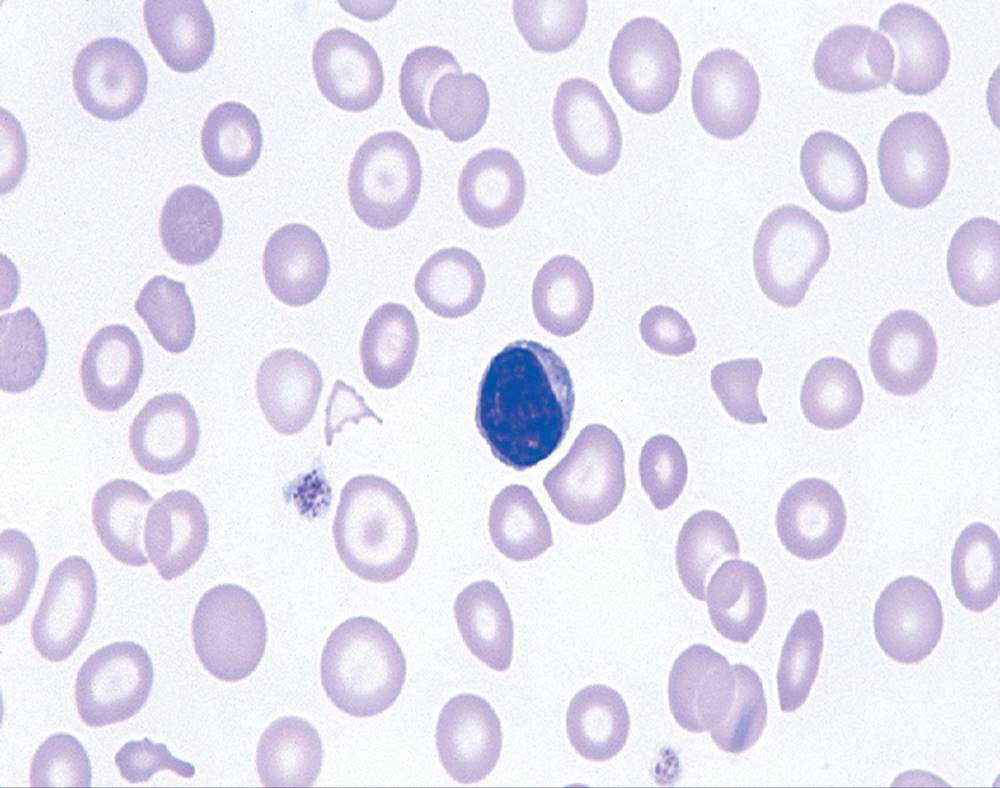
Image

Kathryn Doig
OUTLINE
General Concepts in Anemia
Iron Deficiency Anemia
Etiology
Pathogenesis
Epidemiology
Laboratory Diagnosis
Treatment and Its Effects
Anemia of Chronic Inflammation
Etiology
Laboratory Diagnosis
Treatment
Sideroblastic Anemias
Lead Poisoning
Porphyrias
Iron Overload
Etiology
Pathogenesis
Laboratory Diagnosis
Treatment
Objectives
After completion of this chapter, the reader should be able to:
1. Recognize complete blood count (CBC) results consistent with iron deficiency anemia, anemia of chronic inflammation, and sideroblastic anemias.
2. Given the results of classical iron studies, as well as free erythrocyte protoporphyrin (FEP), soluble transferrin receptor, hemoglobin content of reticulocytes, sTfR/log ferritin, and Thomas plots, distinguish findings consistent with iron deficiency anemia, latent iron deficiency, anemia of chronic inflammation, sideroblastic anemias, and iron overload conditions.
3. Recognize individuals at risk for iron deficiency anemia by virtue of age, gender, diet, physiologic circumstance such as pregnancy and menstruation, or pathologic conditions such as chronic gastrointestinal bleeding.
4. Given a description of a Wright-stained bone marrow smear and the appearance of bone marrow stained with Prussian blue stain, recognize results consistent with iron deficiency anemia, anemia of chronic inflammation, or a sideroblastic anemia.
5. Recognize clinical conditions that can predispose a patient to develop anemia of chronic inflammation.
6. Recognize predisposing factors for sideroblastic anemias or conditions in which sideroblastic anemias may develop.
7. Discuss the clinical significance of increased levels of FEP.
8. Describe the pathogenesis of iron deficiency anemia, anemia of chronic inflammation, sideroblastic anemia secondary to lead poisoning, and hemochromatosis, generically.
9. Discuss the differences in disease etiology, diagnosis, and treatment between iron overload resulting from hereditary forms of hemochromatosis and transfusion-related hemosiderosis.
10. Describe the etiology of the erythropoietic porphyrias, expected CBC picture, diagnostic metabolites, and clinical presentation.
CASE STUDY
After studying the material in this chapter, the reader should be able to respond to the following case study:
An 85-year-old slender, frail white woman was hospitalized for diagnosis and treatment of anemia suspected during a routine examination by her physician. The physician noted that she appeared pale and inquired about fatigue and tiredness. Although the patient generally felt well, she admitted to feeling slightly tired when climbing stairs. A point-of-care hemoglobin performed in the physician’s office showed a dangerously low value of 3.5 g/dL, so the patient was hospitalized for further evaluation. Her hospital CBC results are as follows:
|
Patient Value |
Reference Intervals |
|
|
WBCs (× 109/L) |
8.5 |
4.5–11 |
|
RBCs (× 1012/L) |
1.66 |
4.3–5.9 |
|
HGB (g/dL) |
3.0 |
13.9–16.3 |
|
HCT (%) |
11 |
39–55 |
|
MCV (fL) |
66.3 |
80–100 |
|
MCH (pg) |
18.1 |
26–32 |
|
MCHC (g/dL) |
27.3 |
32–36 |
|
RDW (%) |
20 |
11.5–14.5 |
|
Platelets (× 109/L) |
165.0 |
150–450 |
|
WBC differential |
Unremarkable |
|
|
RBC morphology |
Marked anisocytosis, marked poikilocytosis, marked hypochromia, marked microcytosis |
1. Using the systematic approach to interpretation of a CBC described in Chapters 16 and 19, describe the patient’s blood picture.
2. What causes of anemia should you consider based on the results of the CBC?
3. Assuming that this patient has not been diagnosed with anemia at any other time during her life, can any of the conditions listed in the answer to question 2 be eliminated?
4. Assuming that the patient is otherwise healthy and experiencing only the common declines of sight, hearing, and mobility associated with aging, are any of the conditions listed in the answer to question 2 more likely than the others?
5. What additional testing would you recommend? What results do you expect for this patient?
General concepts in anemia
Anemia may result whenever red blood cell (RBC) production is impaired, RBC life span is shortened, or there is frank loss of cells. The anemias associated with iron and heme typically are categorized as anemias of impaired production resulting from the lack of raw materials for hemoglobin assembly. Depending on the cause, lack of available iron results in iron deficiency anemia or the anemia of chronic inflammation. Inadequate production of protoporphyrin leads to diminished production of heme and thus hemoglobin, but with a relative excess of iron. The result is sideroblastic anemia. These causes are discussed in this chapter. Inadequate globin production results in the thalassemias, which are discussed separately in Chapter 28.
As described more extensively in Chapter 11, iron is absorbed from the diet in the small intestine, carried by transferrin to a cell in need, and brought into the cell, where it is held as ferritin until incorporated into its final functional molecule. That functional molecule may be a heme-based cytochrome, muscle myoglobin, or, in the case of developing RBCs, hemoglobin. Iron may be unavailable for incorporation into heme because of inadequate stores of body iron or impaired mobilization. The anemia associated with inadequate stores is termed iron deficiency anemia, whereas the anemia resulting from impaired iron mobilization is known as anemia of chronic inflammation because of its association with chronic inflammatory conditions, such as rheumatoid arthritis. When the iron supply is adequate and mobilization is unimpaired but an RBC defect or impairment prevents production of protoporphyrin or incorporation of iron into it, the resulting anemia is termed sideroblastic, which refers to the presence of nonheme iron in the developing RBCs. One other form of anemia develops when the porphyrin component of hemoglobin is in short supply as with several of the porphyrias, diseases of impaired porphyrin production. Tests of body iron status are critical in diagnosis of these conditions, so the reader is referred to Chapter 11, where these tests are described in detail.
Iron deficiency anemia
Etiology
Iron deficiency anemia develops when the intake of iron is inadequate to meet a standard level of demand, when the need for iron expands without compensated intake, when there is impaired absorption, or when there is chronic loss of hemoglobin from the body.
Inadequate intake
Iron deficiency anemia can develop when the erythron is slowly starved for iron. Each day, approximately 1 mg of iron is lost from the body, mainly in the mitochondria of desquamated skin and sloughed intestinal epithelium.1 Because the body tenaciously conserves all other iron from senescent cells, including RBCs, daily replacement of 1 mg of iron from the diet maintains iron balance and supplies the body’s need for RBC production as long as there is no other source of loss. When the iron in the diet is consistently inadequate, over time the body’s stores of iron become depleted. Ultimately, RBC production slows as a result of the inability to produce hemoglobin. With approximately 1% of cells dying naturally each day, the anemia becomes apparent when the production rate is insufficient for replacement of lost cells.
Increased need
Iron deficiency can also develop when the level of iron intake is inadequate to meet the needs of an expanding erythron. This is the case in periods of rapid growth, such as infancy (especially in prematurity), childhood, and adolescence. For example, although both infants and adult men need about 1 mg/day of iron, that corresponds to a much higher amount per kilogram of body weight for the infant. Pregnancy and nursing place similar demands on the mother’s body to provide iron for the developing fetus or nursing infant in addition to her own iron needs. In each of these instances, what had previously been an adequate intake of iron for the individual becomes inadequate as the need for iron increases.
Impaired absorption
Even when the diet is adequate in iron, the inability to absorb that iron through the enterocyte into the blood over time will result in a deficiency of iron in the body. The impairments may be pathologic, as with malabsorption due to celiac disease. Others may be inherited mutations of iron regulatory proteins, like the mutations of the matriptase 2 protein (Chapter 11) that lead to a persistent production of hepcidin, causing ferroportin in the enterocyte to be inactivated, thus preventing iron absorption in the intestine.2 In addition, diseases that decrease stomach acidity impair iron absorption by decreasing the capacity to reduce dietary ferric iron to the absorbable ferrous form. Some loss of acidity accompanies normal aging, but gastrectomy or bariatric surgeries can impair iron absorption dramatically. Medications such as antacids can inhibit absorption, and others may even bind the iron in the intestine, preventing its absorption.
Chronic blood loss
A fourth way iron deficiency develops is with chronic hemorrhage or hemolysis that results in the loss of small amounts of heme iron from the body over a prolonged period of time. Eventually anemia develops when the iron loss continually exceeds iron intake and the storage iron is exhausted. Excessive heme iron can be lost through chronic gastrointestinal bleeding from ulcers, gastritis due to alcohol or aspirin ingestion, tumors, parasitosis, diverticulitis, ulcerative colitis, or hemorrhoids. In women, prolonged menorrhagia (heavy menstrual bleeding) or conditions such as fibroid tumors or uterine malignancies can also lead to heme iron loss. Heme iron can also be lost excessively through the urinary tract with kidney stones, tumors, or chronic infections. Individuals with chronic intravascular hemolytic processes, such as paroxysmal nocturnal hemoglobinuria, can develop iron deficiency due to the loss of iron in hemoglobin passed into the urine.
Pathogenesis
Iron deficiency anemia develops slowly, progressing through stages that physiologically blend into one another but are useful delineations for understanding disease progression.3 As shown in Figure 20-1, iron is distributed among three compartments: the storage compartment, principally as ferritin in the bone marrow macrophages and liver cells; the transport compartment of serum transferrin; and the functional compartment of hemoglobin, myoglobin, and cytochromes. Hemoglobin and intracellular ferritin and hemosiderin constitute nearly 90% of the total distribution of iron (Table 11-1).

FIGURE 20-1 Development of iron deficiency anemia. ↑ Increased; ↓, decreased; N, normal; TIBC, total iron-binding capacity. Source: (Adapted from Suominen P, Punnonen K, Rajamäki A, et al: Serum transferrin receptor and transferrin receptor–ferritin index identify healthy subjects with subclinical iron deficits, Blood 92:2934–2939, 1998; reprinted with permission.)
For a period of time as an increase in demand or increased loss of iron exceeds iron intake, essentially normal iron status continues. The body strives to maintain iron balance by accelerating absorption of iron from the intestine through a decrease in the production of hepcidin in the liver. This state of declining body iron with increased absorption is not apparent in routine laboratory test results or patient symptoms. The individual appears healthy. As the negative iron balance continues, however, a stage of iron depletion develops.
Stage 1
Stage 1 of iron deficiency is characterized by a progressive loss of storage iron. RBC development is normal, however, because the body’s reserve of iron is sufficient to maintain the transport and functional compartments through this phase. There is no evidence of iron deficiency in the peripheral blood because RBCs survive 120 days, and the patient does not experience symptoms of anemia. Serum ferritin levels are low, however, which indicates the decline in stored iron, and this also could be detected in an iron stain of the bone marrow. Without evidence of anemia, however, these tests would not be performed because individuals appear healthy. The prevalence of stage 1 iron deficiency in the United States has been estimated at 14.4% for 1- to 2-year-olds, 3.7% for 3- to 5-year-olds, 9.3% for 12- to 19-year-old females, and 9.2% for 20- to 49-year-old females.4 This stage is sometimes called latent or subclinical iron deficiency because the iron stores are inadequate but the hemoglobin value remains normal, and thus the deficiency is unlikely to be recognized.
Stage 2
Stage 2 of iron deficiency is defined by the exhaustion of the storage pool of iron (Figure 20-1). For a time, RBC production continues as normal, relying on the iron available in the transport compartment. Quickly the hemoglobin content of reticulocytes begins to decrease, which reflects the onset of iron deficient erythropoiesis, but because the bulk of the circulating RBCs were produced during the period of adequate iron availability, the overall hemoglobin measurement is still normal. Thus anemia is still not evident, although an individual’s hemoglobin may begin dropping, and the RBC distribution width (RDW) may begin increasing as some smaller RBCs are released from the bone marrow. Other iron-dependent tissues, such as muscles, may begin to be affected, although the symptoms may be nonspecific. The serum iron and serum ferritin levels decrease, whereas total iron-binding capacity (TIBC), an indirect measure of transferrin, increases. Free erythrocyte protoporphyrin (FEP), the porphyrin into which iron is inserted to form heme, begins to accumulate. Transferrin receptors increase on the surface of iron-starved cells as they try to capture as much available iron as possible. They also are shed into the plasma, so the soluble transferrin receptor levels increase measurably. Prussian blue stain of the bone marrow in stage 2 shows essentially no stored iron, and iron deficient erythropoiesis is evident (subsequent description). Hepcidin, though not commonly measured clinically, would be measurably decreased. The hemoglobin content of reticulocytes would begin to drop, demonstrating iron-restricted erythropoiesis. As in stage 1, iron deficiency in stage 2 is still subclinical, and testing is not likely to be undertaken.
Stage 3
Stage 3 of iron deficiency is frank anemia. The hemoglobin concentration and hematocrit are low relative to the reference intervals. Depletion of storage iron and diminished levels of transport iron (Figure 20-1) prevent normal development of RBC precursors. The RBCs become microcytic and hypochromic (Figure 20-2) as their ability to produce hemoglobin is restricted. As expected, serum ferritin levels are exceedingly low. Results of other iron studies (see later) are also abnormal, and the free erythrocyte protoporphyrin and soluble transferrin receptor levels continue to increase. The hemoglobin content of reticulocytes will continue to drop. If measured, erythropoietin would be elevated, while hepcidin would be decreased.
FIGURE 20-2 Peripheral blood film from a patient with hypochromic, microcytic anemia. Note the variation in red blood cell (RBC) diameters compared to the lymphocyte’s nuclear diameter. Variation in RBC diameters is termed anisocytosis and corresponds to an elevated RBC distribution width (RDW), a measure of variation in RBC volume. Hypochromia, microcytosis, and an elevated RDW may indicate iron deficiency anemia. Several target cells are seen.
In this phase, the patient experiences the nonspecific symptoms of anemia, typically fatigue, weakness, and shortness of breath, especially with exertion. Pallor is evident in light-skinned individuals but also can be noted in the conjunctivae, mucous membranes, or palmar creases of dark-skinned individuals. More severe signs are not seen as often in the United States5 but include a sore tongue (glossitis) due to iron deficiency in the rapidly proliferating epithelial cells of the alimentary tract and inflamed cracks at the corners of the mouth (angular cheilosis). Koilonychia (spooning of the fingernails) may be seen if the deficiency is long-standing. Patients also may experience cravings for nonfood items, called pica. The cravings may be for things such as dirt, clay, laundry starch, or, most commonly, ice (craving for the latter is called pagophagia).5
As should be evident from this discussion, numerous individuals may be iron deficient while appearing healthy. Until late in stage 2, they may experience no symptoms at all and are unlikely to come to medical attention. Even in stage 3, frankly anemic patients may not seek medical care, because the body is able to compensate remarkably for slowly developing anemia (Chapter 19), like that in the patient in the case study at the beginning of this chapter. Because results of routine screening tests included in the CBC do not become abnormal until late in stage 2 or early in stage 3, most patients are not diagnosed until relatively late in the progression of the iron depletion.
Epidemiology
From the previous discussion, it is apparent that certain groups of individuals are more prone to develop iron deficiency anemia. Menstruating women are at especially high risk. Their monthly loss of blood increases their routine need for iron, which often is not met with the standard U.S. diet.5 For adolescent girls, this is compounded by increased iron needs associated with growth. If women of childbearing age do not receive proper iron supplementation, pregnancy and nursing can lead to a loss of nearly 900 mg of iron,6 which further depletes iron stores. Succeeding pregnancies can exacerbate the problem, leading to iron deficient fetuses.6
Growing children also are at high risk. Growth requires iron for the cytochromes of all new cells, myoglobin for new muscle cells, and hemoglobin in the additional RBCs needed to supply oxygen for a larger body. The increasing need for iron as the child grows can be coupled with dietary inadequacies, especially in circumstances of poverty or neglect. Cow’s milk is not a good source of iron, and infants need to be placed on iron-supplemented formula by about age 6 months, when their fetal stores of iron become depleted.5 This assumes that the infants were able to establish adequate iron stores by drawing iron from their mothers in utero. Even though breast milk is a better source of iron than cow’s milk,7 it is not a consistent source.8 Therefore, iron supplementation is also recommended for breastfed infants after 6 months of age.5
Iron deficiency is relatively rare in men and postmenopausal women because the body conserves iron so tenaciously, and these individuals lose only about 1 mg/day. Gastrointestinal disease, such as ulcers, tumors, or hemorrhoids, should be suspected in iron deficient patients in either of these groups if the diet is known to be adequate in iron. Regular aspirin ingestion and alcohol consumption can lead to gastritis and chronic bleeding. Elderly individuals, particularly those living alone, may not eat a balanced diet, so pure dietary deficiency is seen among these individuals. In some elderly individuals, the loss of gastric acidity with age can impair iron absorption. Iron deficiency is associated with infection by hookworms, Necator americanus and Ancylostoma duodenale. The worm attaches to the intestinal wall and literally sucks blood from the gastric vessels. Iron deficiency is also associated with infection with other parasites, such as Trichuris trichiura, Schistosoma mansoni, and Schistosoma haematobium, in which the heme iron is lost from the body due to intestinal or urinary bleeding.
Soldiers subjected to prolonged maneuvers and long-distance runners also can develop iron deficiency. Exercise-induced hemoglobinuria, also called march hemoglobinuria, develops when RBCs are hemolyzed by foot-pounding trauma and iron is lost as hemoglobin in the urine.9 The amount lost in the urine can be so little that it is not apparent on visual inspection of the urine. Nevertheless, in rare cases, the cumulative iron loss can lead to anemia if the foot-pounding trauma is recurrent and especially severe.
Laboratory diagnosis
Iron deficiency can be readily diagnosed in later stages using routine tests. Detection in the early stages requires sophisticated tests, but individuals are unlikely to be referred for such studies because there is virtually no physiologic evidence of the declining iron state. Nevertheless, early iron deficiency might be suspected in an individual in a high-risk group, and appropriate testing can be ordered.9 The tests for iron deficiency can be grouped into three general categories: screening, diagnostic, and specialized. The principles are discussed in more detail in Chapter 11.
Screening for iron deficiency anemia
When iron deficient erythropoiesis is under way, the CBC results begin to show evidence of anisocytosis, microcytosis, and hypochromia (Figure 20-2). The classic picture of iron deficiency anemia in stage 3 includes a decreased hemoglobin level. An RDW greater than 15% is expected and may precede the decrease in hemoglobin.10 For patients in high-risk groups, the elevated RDW can be an early and sensitive indicator of iron deficiency that is provided in a routine CBC.11 As the hemoglobin level continues to fall, microcytosis and hypochromia become more prominent, with progressively declining values for mean cell volume (MCV), mean cell hemoglobin (MCH), and mean cell hemoglobin concentration (MCHC). The RBC count ultimately becomes decreased, as does the hematocrit. Polychromasia may be apparent early, although it is not a prominent finding. A low absolute reticulocyte count confirms a diminished rate of effective erythropoiesis because this is a nonregenerative anemia.12 Poikilocytosis, including occasional target cells and elliptocytes, may be present, although no particular shape is characteristic or predominant. Thrombocytosis may be present, particularly if the iron deficiency results from chronic bleeding, but this is not a diagnostic parameter. White blood cells (WBCs) are typically normal in number and appearance. Iron deficiency should be suspected when the CBC findings show a hypochromic, microcytic anemia with an elevated RDW but no consistent shape changes to the RBCs.
Diagnosis of iron deficiency
Iron studies remain the backbone for diagnosis of iron deficiency. They include assays of serum iron, total iron-binding capacity (TIBC), transferrin saturation, and serum ferritin; Chapter 11 covers the principle of each assay and technical considerations affecting test performance and interpretation. Serum iron is a measure of the amount of iron bound to transferrin (transport protein) in the serum. TIBC is an indirect measure of transferrin and the available binding sites for iron in the plasma. The percent of transferrin saturated with iron can be calculated from the total iron and the TIBC:

Ferritin is not truly an extracellular protein because it provides an intracellular storage repository for metabolically active iron. However, ferritin is present in serum, and serum levels reflect the levels of iron stored within cells. Serum ferritin is an easily accessible surrogate for stainable bone marrow iron. The iron studies are used collectively to assess the iron status of an individual. shows that, as expected, serum ferritin and serum iron values are decreased in iron deficiency anemia, a state called sideropenia. Transferrin levels increase when the hepatocytes detect low iron levels, and research shows that this is a transcriptional and posttranslational response to low iron levels.Table 20-113 The result is a decline in the iron saturation of transferrin that is more dramatic than might be expected simply from the decrease in serum iron level.
TABLE 20-1
Results of Iron Studies in Microcytic, Hypochromic Anemias
|
Iron Deficiency |
Thalassemia Minor |
Anemia of Chronic Inflammation |
Sideroblastic Anemia |
Lead Poisoning |
|
|
Serum ferritin |
/N |
/N |
N |
||
|
Serum iron |
/N |
/N |
Variable |
||
|
TIBC |
N |
/N |
N |
||
|
Transferrin saturation |
/N |
/N |
|||
|
FEP/ZPP |
N |
(marked) |
|||
|
BM iron (Prussian blue reaction) |
No stainable iron |
/N |
/N |
N |
|
|
Sideroblasts in BM |
None |
N |
None/very few |
(ring) |
N (ring) |
|
Other special tests |
Hb A2 (β-thalassemia minor) |
Specific tests for inflammatory disorders or cancer |
ALA in urine ↑ Whole-blood lead levels |
↑, Increased; ↓, decreased; ALA, aminolevulinic acid; BM, bone marrow; FEP/ZPP, free erythrocyte protoporphyrin/zinc protoporphyrin; Hb, hemoglobin; N, normal.
The amount of hemoglobin in reticulocytes can be assessed on some automated hematology analyzers (Chapter 15).14 The hemoglobin content of reticulocytes is analogous to the MCH, but for reticulocytes only. The MCH is the average weight of hemoglobin per cell across the entire RBC population. Some of the RBCs are nearly 120 days old, whereas others are just 1 to 2 days old. If iron deficiency is developing, the MCH does not change until a substantial proportion of the cells are iron deficient, and the diagnosis is effectively delayed for weeks or months after iron deficient erythropoiesis begins. Measuring the hemoglobin content of reticulocytes enables detection of iron-restricted erythropoiesis within days as the first iron deficient cells leave the bone marrow. It is a sensitive indicator of iron deficiency. Even in stage 2 of iron deficiency, before anemia is apparent, the hemoglobin content of reticulocytes will be low.14
Specialized tests
Other tests, although not commonly used for the diagnosis of iron deficiency, show abnormalities that become important in the differential diagnosis of similar conditions. Test results for the accumulated porphyrin precursors to heme are elevated (Table 20-1). Free erythrocyte protoporphyrin accumulates when iron is unavailable. In the absence of iron, free erythrocyte protoporphyrin may be preferentially chelated with zinc to form zinc protoporphyrin (ZPP).15 The FEP and zinc chelate can be assayed fluorometrically, although they are not particularly valuable in the diagnosis of iron deficiency. Soluble transferrin receptors (sTfR) also can be assayed using immunoassay. Levels increase as the disease progresses, and individual cells seek to take in as much iron as possible.16
A bone marrow assessment is not indicated for suspected uncomplicated iron deficiency. A therapeutic trial of iron (see Response to Treatment) provides a less invasive and less expensive diagnostic assessment. However, marrow examination for iron is routinely performed when a bone marrow sample is indicated for other reasons. With routine stains, the iron deficient bone marrow appears hyperplastic early in the progression of the disease, with a decreased myeloid-to-erythroid ratio as a result of increased erythropoiesis.5 As the disease progresses, hyperplasia subsides, and the profound deficiency of iron leads to slowed RBC production. Polychromatic normoblasts (i.e., rubricytes) show the most dramatic morphologic changes (Figure 20-3). Nuclear-cytoplasmic asynchrony is evident, with cytoplasmic maturation lagging behind nuclear maturation. Without the pink provided by hemoglobin, the cytoplasm remains bluish after the nucleus has begun to condense. The cell membranes appear irregular and are usually described as “shaggy.”

FIGURE 20-3 Bone marrow smear from a patient with iron deficiency anemia. The late-nucleated red blood cells show the characteristic “shaggy” blue cytoplasm due to asynchrony in maturation (×1000). Source: (Courtesy Ann Bell, University of Tennessee, Memphis.)
Treatment and its effects
Treatment
The first therapy for iron deficiency is to treat any underlying contributing cause, such as hookworms, tumors, or ulcers. As in the treatment of simple nutritional deficiencies or increased need, dietary supplementation is necessary to replenish the body’s iron stores. Oral supplements of ferrous sulfate (3 tablets/day containing 65 mg of elemental iron) are the standard prescription.5 The supplements should be taken on an empty stomach to maximize absorption. Many patients experience side effects such as nausea and constipation, however, which leads to poor patient compliance. Vigilance on the part of the health care providers is important to ensure that patients complete the course of iron replacement, which usually lasts 6 months or longer.17 In rare cases in which intestinal absorption of iron is impaired (for example, in conditions like gastric achlorhydria, celiac disease, or with mutations like those in matriptase-2) parenteral administration of iron dextrans can be used, although the side effects of this therapy are notable.5Because of the risks associated with red blood cell transfusions, they are rarely warranted for the correction of uncomplicated iron deficiency unless the patient’s hemoglobin level has become dangerously low, like the patient in this chapter’s case study.
Response to treatment
When optimal treatment with iron is initiated, the effects are quickly evident. Reticulocyte hemoglobin content will correct within 2 days.14 Reticulocyte counts (relative and absolute) begin to increase within 5 to 10 days.17 The anticipated rise in hemoglobin appears in 2 to 3 weeks, and levels should return to normal for the individual by about 2 months after the initiation of adequate treatment.18 The peripheral blood film and indices still reflect the microcytic RBC population for several months, with a biphasic population including the younger normocytic cells. The normocytic population eventually predominates. Iron therapy must continue for another 3 to 4 months to replenish the storage pool and prevent a relapse.
It is common and reasonable for care providers to assume that iron deficiency is due to dietary deficiency because that is the case in most instances of iron deficiency. Thus supplementation should correct it. If the patient has been adherent to the therapeutic regimen, the failure to respond to iron treatment points to the need for further investigation. The patient may be experiencing continued occult loss of blood or inadequate absorption, justifying additional diagnostics. Alternatively, causes of hypochromic, microcytic anemia unrelated to iron deficiency, such as thalassemia, should be considered.
Anemia of chronic inflammation
Anemia is commonly associated with systemic diseases, including chronic inflammatory conditions such as rheumatoid arthritis, chronic infections such as tuberculosis or human immunodeficiency virus infection, and malignancies. Cartwright19 was the first to suggest that although the underlying diseases seem quite disparate, the associated anemia may be from a single cause, proposing the concept of anemia of chronic disease. This anemia represents the most common anemia among hospitalized patients.20
Etiology
Although the anemia associated with chronic systemic disorders was originally called anemia of chronic disease, chronic blood loss is not among the conditions leading to the anemia of chronic disease. Chronic blood loss results in clear-cut iron deficiency. Anemia of chronic disease is more correctly termed anemia of chronic inflammation (ACI), because inflammation is the unifying factor among the three aforementioned general types of conditions in which this anemia is seen. The central feature of anemia of chronic inflammation is sideropenia in the face of abundant iron stores. The cause is now understood to be largely impaired ferrokinetics.
The apparent inconsistency of decreased serum iron but abundant iron stores is explained by the role of hepcidin in regulation of body iron (Chapter 11). Hepcidin is a hormone produced by hepatocytes to regulate body iron levels, particularly absorption of iron in the intestine and release of iron from macrophages. Hepcidin interacts with and causes the degradation of the transmembrane protein ferroportin, which exports iron from enterocytes into the plasma, reducing the amount of iron absorbed into the blood from the intestine.21 Macrophages and hepatocytes also use ferroportin to export iron into plasma and are affected by hepcidin.21, 22 When systemic body iron levels decrease, hepcidin production by hepatocytes decreases,23 and enterocytes export more iron into the plasma. Macrophage and hepatocyte release of iron also increases. When systemic iron levels are high, hepcidin increases, enterocytes export less iron into the plasma, and macrophages and hepatocytes retain iron.
Hepcidin is an acute phase reactant.24 During inflammation, the liver increases the synthesis of hepcidin in response to interleukin-6 produced by activated macrophages. This increase occurs regardless of systemic iron levels in the body. As a result, during inflammation, there is a decrease in iron absorption from the intestine and iron release from macrophages and hepatocytes (Figure 20-4). Although there is plenty of iron in the body, it is unavailable to developing RBCs because it is sequestered in the macrophages and hepatocytes.

FIGURE 20-4 Mechanisms of anemia in chronic inflammatory conditions. Chronic infections (bacterial, viral, parasitic, or fungal), malignancy, or autoimmune dysregulation result in the release of inflammatory cytokines from activated macrophages and T lymphocytes. Interleukin-6 (IL-6) promotes liver production of hepcidin, an acute phase reactant that impairs iron absorption in intestinal enterocytes and iron release from macrophages and hepatocytes. Inflammatory cytokines, such as tumor necrosis factor-α (TNF-α), interleukin-1 (IL-1), and interferon-γ (INF-γ), also inhibit erythropoiesis and decrease erythropoietin (EPO) production by the kidney. Although these latter mechanisms contribute to the anemia of chronic inflammation, the hepcidin-induced inhibition of intestinal iron absorption and iron release from storage sites in macrophages and hepatocytes is the more significant cause of the anemia.Source: (Adapted from Weiss G, Goodnough LT. Anemia of chronic disease. N Eng J Med 352, 2005, p. 1013.)
This response of hepcidin during inflammation is likely a nonspecific defense against invading bacteria. If the body can sequester iron, it reduces the amount of iron available to bacteria and contributes to their demise. Although this response of hepcidin is not harmful during disorders of short duration, chronically high levels of hepcidin sequester iron for long periods, which leads to diminished production of RBCs.
A second acute phase reactant seems to contribute to anemia of chronic inflammation, although probably to a much smaller extent than hepcidin. Lactoferrin is an iron-binding protein in the granules of neutrophils. Its avidity for iron is greater than that of transferrin. Lactoferrin is important intracellularly for phagocytes to prevent phagocytized bacteria from using intracellular iron for their metabolic processes.25 During infection and inflammation, however, neutrophil lactoferrin also is released into the plasma. There it scavenges available iron, at the expense of transferrin. When it is carrying iron, the lactoferrin becomes bound to macrophages and liver cells that salvage the iron. RBCs are deprived of this source of plasma iron, however, because they do not have lactoferrin receptors.
Finally, a third acute phase reactant, ferritin, contributes to the anemia of chronic inflammation. Increased levels of ferritin in the plasma also bind some iron. Because developing RBCs do not have a ferritin receptor, this iron is also unavailable for incorporation into hemoglobin.
The result of these effects is that although iron is present in abundance in bone marrow macrophages, its release to developing erythrocytes is slowed. This can be seen histologically with iron stains that show iron in macrophages but not in erythroblasts (Figure 17-14, C).26 The effect on the developing RBCs is essentially no different from that in mild iron deficiency because they are effectively deprived of the iron. Like iron deficiency anemia, this is iron-restricted erythropoiesis.
Production of inflammatory cytokines (such as tissue necrosis factor-α and interleukin-1 from activated macrophages and interferon-γ from activated T-cells) also impairs proliferation of erythroid progenitor cells, diminishes their response to erythropoietin, and decreases production of erythropoietin by the kidney (Figure 20-4).27 Although these mechanisms contribute to the anemia of chronic inflammation, the impaired ferrokinetics is the more significant cause of the anemia.
Laboratory diagnosis
The peripheral blood picture in anemia of chronic inflammation is that of a mild anemia, with hemoglobin concentration usually 8 to 10 g/dL and without reticulocytosis. The cells are usually normocytic and normochromic, although microcytosis and hypochromia develop in about one third of patients and may represent coexistent iron deficiency.28 The inflammatory condition leading to the anemia also may cause leukocytosis, thrombocytosis, or both. Iron studies (Table 20-1) show low serum iron and TIBC values. Because hepatocyte production of transferrin is regulated by intracellular iron levels, the low TIBC (an indirect measure of transferrin) reflects the abundant iron stores in the body. The transferrin saturation may be normal or low. The serum ferritin level is usually increased beyond the value that would be expected for the same patient in the absence of the inflammatory condition. It may not be outside the reference interval, but it is nevertheless increased. The failure to incorporate iron into heme results in elevation of free erythrocyte protoporphyrin, although this test typically is not used diagnostically. The hemoglobin content of reticulocytes will be decreased, reflecting the iron restricted hematopoiesis, but the soluble transferrin receptor will be normal, reflecting normal intracellular iron. The bone marrow shows hypoproliferation of the RBCs, consistent with the lack of reticulocytes in the peripheral blood. Prussian blue stain of the bone marrow confirms abundant stores of iron in macrophages, although not in RBC precursors, but bone marrow examination is not usually required in the diagnostic evaluation.
Patients with iron deficiency anemia who have an inflammatory condition present a special diagnostic dilemma. The iron deficiency may be missed because of the increase in serum ferritin levels associated with the inflammation. Serum ferritin values generally in the 30 to 100 ng/mL range are most equivocal.27 Iron deficiency anemia and anemia of chronic inflammation may be distinguished in such situations, or their coexistence can be verified, by measuring soluble transferrin receptors (sTfRs) in the serum.29 These receptors are sloughed from cells into the plasma. As noted earlier, levels increase during iron deficiency anemia but remain essentially normal during anemia of chronic inflammation.
Additional modifications to the use of the sTfR have been developed to better distinguish iron deficiency, latent iron deficiency, and ACI. The principles of these assays and calculations are discussed in Chapter 11and the measurement of the hemoglobin content of reticulocytes is discussed in Chapter 15. It is expected that the sTfR/log ferritin will rise most dramatically in iron deficiency as the numerator rises and the denominator falls; in ACI, both remain essentially normal, and thus a normal ratio results (Figure 20-5).30 The hemoglobin content of reticulocytes will be reduced in both iron deficiency and ACI. However, when graphed against the sTfR/log ferritin in a Thomas plot (Figure 11-6), the two conditions may be distinguished, sometimes better than with the sTfR/log ferritin alone (Chapter 11).31, 32 Additional research should help resolve this diagnostic dilemma.

FIGURE 20-5 Algorithm for diagnosis and differentiation of iron deficiency anemia and the anemia of chronic inflammation (disease). Patients with iron deficiency may exhibit normal ferritin levels in the range of 30 to 100 ng/mL when there is a rise of ferritin due to coexistent anemia of chronic inflammation (disease). Use of the soluble transferrin receptor assay in conjunction with ferritin can help distinguish these conditions or establish their coexistence. sTfR, Soluble transferrin receptor in mg/L. Source: (Adapted from Weiss G, Goodnough LT. Anemia of chronic disease. N Eng J Med 352, 2005, p. 1020.)
Treatment
Therapeutic administration of erythropoietin can correct anemia of chronic inflammation,33 but iron must be administered concurrently because stored body iron remains sequestered and unavailable.34 The anemia is typically not severe, however, and this costly treatment is warranted only in select patients. The best course of treatment is effective control or alleviation of the underlying condition.
Sideroblastic anemias
Just as anemia can result from inadequate supplies of iron for production of hemoglobin, diseases that interfere with the production of adequate amounts of protoporphyrin also can produce anemia. (Chapter 10covers heme synthesis.) As in iron deficiency, the anemia may be microcytic and hypochromic. In contrast to iron deficiency, however, iron is abundant in the bone marrow. A Prussian blue stain of the bone marrow shows normoblasts with iron deposits in the mitochondria surrounding the nucleus. Its presence in the mitochondria shows that the iron is awaiting incorporation into heme. These ring sideroblasts are the hallmark of the sideroblastic anemias (Figure 20-6).

FIGURE 20-6 Ring sideroblasts (arrows) in bone marrow shown with Prussian blue stain (×1000).
The sideroblastic anemias are a diverse group of diseases that include hereditary and acquired conditions (). Among the hereditary forms, X-linked and autosomal varieties of this condition are known. Some patients experience at least modest improvement of anemia with pharmacologic doses of pyridoxine to stimulate heme synthesis.Box 20-135 Pyridoxine is a cofactor in the first step of porphyrin synthesis (Figure 10-5) in which glycine is condensed with succinyl coenzyme A to form aminolevulinic acid.
BOX 20-1
Disorders Included in Sideroblastic Anemias
Hereditary
X-linked
Autosomal
Acquired
Primary sideroblastic anemia (refractory)
Secondary sideroblastic anemias caused by drugs and bone marrow toxins
• Antitubercular drugs
• Chloramphenicol
• Alcohol
• Lead
• Chemotherapeutic agents
Lead poisoning
The acquired conditions leading to sideroblastic anemia constitute a diverse group in themselves. Certain drugs, such as chloramphenicol or isoniazid, can induce sideroblastic anemia.36 Other toxins, including heavy metals, also have been implicated. Among these, lead is a significant public health concern. Adults may be exposed at work to leaded compounds. Adults and children living in older homes can be exposed to lead from paints produced before the 1970s. They are at risk if dust is created during renovations or paint is permitted to peel. Toddlers and crawling infants are at special risk from getting dust on their hands and placing them in their mouths. Although anyone can experience lead poisoning, it is of special concern in children because the metal affects the central nervous system and the hematologic system, leading to impaired mental development as well as anemia.37 In children and adults with lead poisoning, a peripheral neuropathy38 can be seen with abdominal cramping and vomiting or seizures.
Lead interferes with porphyrin synthesis at several steps. The most critical are as follows (Figure 10-5):
1. The conversion of aminolevulinic acid (ALA) to porphobilinogen (PBG) by ALA dehydratase (also called PBG synthase); the result is the accumulation of aminolevulinic acid.
2. The incorporation of iron into protoporphyrin IX by ferrochelatase (also called heme synthase); the result is accumulation of iron and protoporphyrin.39
Accumulated aminolevulinic acid is measurable in the urine, and protoporphyrin is measurable in an extract of RBCs as free erythrocyte protoporphyrin or zinc protoporphyrin. Chapter 11 covers the principles of these assays.
Anemia, when present in lead poisoning, is most often normocytic and normochromic; however, with chronic exposure to lead, a microcytic, hypochromic clinical picture may be seen. The degree of anemia in adults may not be dramatic, but in children it may be more profound. The reticulocyte count in acute poisoning may be quite elevated, which suggests that the anemia has a hemolytic component. The presence of a hemolytic component is supported by studies showing impairment of the pentose-phosphate shunt by lead,40 which makes the cells sensitive to oxidant stress as in glucose-6-phosphate dehydrogenase deficiency (Chapter 24). Although the bone marrow may show erythroid hyperplasia, consistent with the elevated reticulocyte count, in some patients it may be hypoplastic.41 Basophilic stippling is a classic finding associated with lead toxicity. Lead inhibits pyrimidine 5′-nucleotidase, an enzyme involved in the breakdown of ribosomal ribonucleic acid (RNA) in reticulocytes.42 This causes undegraded ribosomes to aggregate, forming basophilic stippling. The size of the aggregates in lead poisoning is typically large, so the stippling is heavier than that seen in many anemias and thus represents truly punctate basophilia. Because basophilic stippling is also seen in other anemias, this is not a pathognomonic finding but an expected finding, and whenever basophilic stippling is seen, lead poisoning should be under consideration.
Removal of the drug or toxin is usually successful for the treatment of acquired sideroblastic anemias. In the case of lead, salts of ethylenediaminetetraacetic acid (EDTA) are often used to chelate the lead present in the body so it can be excreted in the urine.41
Porphyrias
Lead poisoning is an example not only of an acquired sideroblastic anemia but also of an acquired porphyria. The porphyrias are diseases characterized by impaired production of the porphyrin component of heme. The impairments to heme synthesis may be acquired, as with lead poisoning, or hereditary. The term porphyria is most often used to refer to the hereditary conditions that impair production of protoporphyrin. Among the inherited disorders, single deficiencies of most enzymes in the synthetic pathway for heme have been identified (Figure 10-5). Although even the autosomal dominant conditions are relatively rare, the disease has been influential historically. The intermarrying European monarchies of past centuries were plagued with some variants of the porphyrias in which psychosis is a prominent clinical feature.
When an enzyme in heme synthesis is missing, the products from earlier stages in the pathway accumulate in cells that actively produce heme, such as erythrocytes and hepatocytes. The excess porphyrins leak from the cells as they age or die, and may be excreted in urine or feces, which allows diagnosis. The accumulated products also deposit in body tissues. Some of the accumulated products are fluorescent. Their deposition in skin can lead to photosensitivity with severe burns upon exposure to sunlight. Accumulation during childhood leads to fluorescence of developing teeth and bones. Only three of the porphyrias have hematologic manifestations; the others have a greater effect on liver cells. Even in those with hematologic effects, the hematologic impact is relatively minimal, and photosensitivity is a greater clinical problem. The fluorescence of some accumulated compounds can be used diagnostically—for example, to measure free erythrocyte protoporphyrin (Chapter 11). In a sample of bone marrow, the erythroblasts will be bright red under a fluorescent microscope. Table 20-2 summarizes the deficient enzymes, affected genes, inheritance, and clinical and laboratory features that can be used in the diagnosis of the hematologically significant porphyrias.
TABLE 20-2
Erythropoietic Porphyrias
|
Congenital Erythropoietic Porphyria (CEP) |
Erythropoietic Protoporphyria (EPP) |
X-linked Erythropoietic Protoporphyria (XLEPP) |
||
|
Enzyme affected |
Uroporphyrinogen III synthase deficiency |
Ferrochelatase deficiency |
ALA-synthase 2 (gain of function) |
|
|
Affected gene |
UROS |
FECH |
ALAS2 |
|
|
Inheritance |
Autosomal recessive |
Autosomal dominant |
X-linked dominant |
|
|
Clinical features |
Photosensitivity, hemolytic anemia |
Photosensitivity; anemia is mild if present |
Photosensitivity; mild microcytic, hypochromic anemia with reticulocyte response is possible |
|
|
Laboratory features |
||||
|
Red blood cells |
Protoporphyrin |
N ↑↑↑ ↑↑ |
↑↑ |
|
|
Urine |
Porphobilinogen |
N ↑↑↑ ↑↑ |
N |
N |
|
Feces |
Protoporphyrin |
N ↑ |
↑ |
N or ↑ |
|
Confirmatory tests |
↓↓ Uroporphyrinogen III synthase activity |
↓ Ferrochelatase activity |
↑ ALA-synthase activity; ↑↑ free erythrocyte protoporphyrin and zinc protoporphyrin |
|
Adapted from Desnick RJ, Balwani M: The porphyrias. In Longo DL, Fauci AS, Kasper DL, et al., eds: Harrison’s principles of internal medicine, 18th ed., New York, 2012, McGraw Hill, chap. 358. Available at: http://www.accessmedicine.com.proxy1.cl.msu.edu/content.aspx?aid=9144015. Accessed November 24, 2013.
↑, Minimally increased levels; ↑↑, moderately increased levels; ↑↑↑, markedly increased levels; ↓↓, moderately decreased levels; ↓↓↓, markedly decreased levels.
Iron overload
Chapter 11 describes the body’s tenacity in conserving iron. For some individuals, this tenacity becomes the basis for disease related to excess iron accumulations in nearly all cells. Iron overload may be primary, as in hereditary hemochromatosis, or secondary to chronic anemias and their treatments. In both cases, the toxic effects of excess iron lead to serious health problems as lipids, proteins, and heme iron become oxidized.
Etiology
Excess accumulation of iron results from acquired or hereditary conditions in which the body’s rate of iron acquisition exceeds the rate of loss, which is usually about 1 mg/day. Regardless of the source of the iron, the body’s first reaction is to store excess iron in the form of ferritin and, ultimately, hemosiderin within cells. Eventually the storage system is overwhelmed, and, as described later, parenchymal cells are damaged in organs such as the liver, heart, and pancreas.
Accumulation of excess iron may be an acquired condition. It occurs when there is a need for repeated transfusions, as in the treatment of anemias such as sickle cell anemia and β-thalassemia major (Chapters 27and 28). The iron present in the transfused RBCs exceeds the usual 1 mg/day of iron typically added to the body’s stores by a healthy diet. This is sometimes called transfusion-related hemosiderosis.
Hemochromatosis may develop as a result of mutations to genes for the proteins of iron metabolism (Table 11-2) so that the feedback regulation of iron is impaired and the body continues to absorb iron, even when stores are full. An autosomal recessive disease was recognized for many years before modern methods allowed a molecular investigation of its cause. In the mid-1990s, a mutation was identified affecting the hereditary hemochromatosis (HFE) protein,43 and shortly after that, additional mutations of the same gene were identified.44, 45 With reliable and specific molecular tests, individuals with the phenotypic disease (i.e., excess iron deposition in tissues) were soon discovered who did not have the HFE mutations. Trying to explain their diseases led to discovery of the other proteins that we now know are involved in iron metabolism. What has emerged is a picture of hereditary hemochromatosis as a general phenotype that can be produced by various genotypes when a gene for an iron regulatory protein is mutated (Table 20-3). The biologic default is to absorb and store iron, and the regulatory mechanisms typically dampen that process. Failure of normal regulation due to mutations leads to excessive absorption and storage, causing the diseases collectively known as the hereditary hemochromatoses. Although substantial understanding of the proteins involved in iron kinetics has emerged in the past 2 decades, likely more remains to be discovered.
TABLE 20-3
Known Mutations Producing Hemochromatosis Phenotypes
|
Feature |
Hemochromatosis, Type 1 (HFE-Associated Hereditary Hemochromatosis) |
Hemochromatosis, Type 2A Juvenile (HFE2-Related Juvenile Hemochromatosis) |
Hemochromatosis, Type 2B Juvenile (HAMP-Related Juvenile Hemochromatosis) |
Hemochromatosis, Type 3 (TFR2-Related Hereditary Hemochromatosis) |
Hemachromatosis, Type 4 (Ferroportin-Related Iron Overload) |
Hemachromatosis, Type 5 |
|
Affected gene |
HFE |
HFE2 (HJV) |
HAMP |
TFR2 |
SLC40A1 |
FTH1 |
|
Mutated protein |
Hereditary hemochromatosis protein |
Hemojuvelin |
Hepcidin |
Transferrin receptor protein 2 |
Solute carrier family 40 member 1 (Ferroportin-1) |
Ferritin heavy chain |
|
Normal function of affected protein |
Inhibits TfR1-mediated iron uptake; regulates hepcidin expression |
Regulates hepcidin expression |
Downregulates ferroportin-mediated iron transport in macrophages and enterocytes |
Provides hepatocyte iron uptake; regulates hepcidin expression |
Transports iron out of enterocytes and macrophages |
Iron storage |
|
Age of onset of symptoms (yr) |
30–40 |
Teens–20 |
Teens–20 |
20–40, mild |
30–40 |
* |
* Found in three members of a Japanese family.
Names of hemochromatosis types from Online Mendelian Inheritance of Man: http://omim.org/entry/235200?search5HFE& highlight5hfe. Accessed December 31, 2013. Approved gene symbols from The Human Genome Organization (HUGO) Gene Nomenclature Committee (HGNC): http://www.genenames.org. Approved protein names from Uni Prot KB, 2002–2014 UniProt Consortium: http://www.uniprot.org.
TfR1, Transferrin receptor 1; TfR2, transferrin receptor 2.
Table 20-3 describes each of the known forms of hemochromatosis, its mutated protein, age of onset, and the nature of the mutation and its effect. As mutations of HFE remain the most common, that form of the disease will be discussed here with some references to differences seen in other forms of the disease. However, in general, all the hereditary hemochromatoses involve mutated proteins that impair hepcidin regulation of ferroportin activity.
Homozygous hereditary hemochromatosis involving the HFE gene occurs in approximately 5 of 1000 northern Europeans.46 Heterozygosity approaches 13%.46 The first two mutations known to produce the hereditary hemochromatosis phenotype involve HFE, a gene on the short arm of chromosome 6 that encodes an HLA class I–like molecule that is closely linked to HLA-A.43 The most common of the two mutations substitutes tyrosine for cysteine at position 282 (Cys282Tyr or C282Y), while the other substitutes aspartate for histidine at position 63 (His63Asp or H63D).44 Other mutations are now known.45 The normal HFE protein binds β2-microglobulin intracellularly.44 This binding is necessary for the HFE to appear on the cell surface, where it interacts with transferrin receptor 1 (TfR1). HFE is bound to TfR1 until TfR1 binds transferrin, and then the HFE is released. It subsequently binds to transferrin receptor 2 (TfR2), which initiates a signal for hepcidin production, ultimately reducing iron absorption. The mutated HFE molecule either does not bind β2-microglobulin and thus does not reach the cell surface or it does not bind TfR1 or TfR2 if it does reach the cell surface.47 In either case, the result is that when HFE protein is mutated, the TfR2-mediated signal to produce hepcidin is diminished. Without hepcidin, ferroportin in the intestinal enterocyte membrane is continually active and absorbing iron, even when the body stores are replete.
Pathogenesis
The processes described previously lead to increased amounts of iron in parenchymal cells throughout the body. The first cellular reaction to excess iron is to form ferritin and ultimately hemosiderin, essentially a degenerate and non–metabolically active form of ferritin. When cells exhaust the capacity to store iron as hemosiderin, free iron (ferrous) accumulates intracellularly. In the presence of oxygen, ferrous iron initiates the generation of superoxide and other free radicals, which results in the peroxidation of membrane lipids (Chapter 11).48 The membranes affected include not only the cell membranes but also mitochondrial, nuclear, and lysosomal membranes. Cell respiration is compromised, and lysosomal enzymes are released intracellularly. Vitamins E and C can act to moderate the effects and interrupt the chain reaction, but in iron overload, even these protective mechanisms are overwhelmed. The ultimate result is cell death due to irreversible membrane damage.
Because all cells except mature RBCs require iron and have the cellular machinery for iron acquisition, most cells have the potential for iron damage. The tissues most obviously affected are the skin, where deposition of hemosiderin gives the skin a golden color; the liver, where cirrhosis-induced jaundice and subsequent cancer develop; and the pancreas, where damage results in diabetes mellitus. Hence the traditional characterization of hemochromatosis is “bronzed diabetes.” The heart muscle also is especially vulnerable to excessive iron deposition, which leads to congestive heart failure. Early diagnosis and treatment (see later) can prevent the development of these secondary effects of iron overload. Hepatocellular carcinoma occurs more frequently in patients with hemochromatosis. Mutations of the p53 tumor suppressor gene seem to contribute to the pathogenesis of the carcinoma,49 and there is some evidence that the free radicals produced by the iron cause the mutations in the p53 gene.50
The disease (i.e., hemochromatosis phenotype) is rarer than the C282Y gene frequency predicts, so the penetrance of the genes is not heavy.46 Other factors also affect the development of clinical disease, including the particular mutation, zygosity, presence of other physiologic conditions, diet, and other environmental influences.
In classic hereditary hemochromatosis (HFE mutations), individuals usually harbor 20 to 30 g of iron by the time their disease becomes clinically evident at the age of 40 to 60 years.51 This is more than 10 times the amount of stored iron in normal individuals and represents just 1 to 2 mg/day of excess iron absorbed over many years.52 In the juvenile forms of the disease associated with mutations to the hepcidin or hemojuvelin genes, the process of iron accumulation is accelerated, so these effects may appear as early as the teenage years.
In the slower-developing diseases, phenotypic expression of the tissue damage in hereditary hemochromatosis is more common in men, although the gene frequency of HFE mutations is not higher in men. This is because the blood loss associated with menstruation and childbirth forestalls the effects of excess iron in affected women, and they usually develop clinical symptoms later in life than affected men. In each sex, homozygous individuals develop disease faster than heterozygotes.
The amount of iron available in the diet for absorption affects the rate at which disease can develop. Substances that can promote iron absorption even in normal individuals, such as ascorbic acid and alcohol, also affect absorption in individuals with hemochromatosis. In transfusion-related hemosiderosis, the frequency of transfusions over time affects the rate of development of clinical disease.
Laboratory diagnosis
Laboratory testing in hemochromatosis serves four purposes. It can be used to screen for the condition, diagnose the cause of organ damage, pinpoint the mutation for family genetic counseling, and monitor treatment. Elevations of transferrin saturation or serum ferritin can be used as a screening test for hereditary hemochromatosis.53 Although screening was estimated to be performed cost-effectively in populations with a disease prevalence of at least 3 per 1000,54 large-scale screening programs remain controversial, even in Europe, where the incidence of the disease is high.55
Individuals with undiagnosed hereditary hemochromatosis may come to medical attention because of organ function problems leading to nonspecific physical complaints (e.g., abdominal pain), or the disease may be discovered incidentally with routine laboratory testing. Abnormal results on common tests of liver function (e.g., elevated alanine transaminase levels) may be among the first laboratory findings that lead a physician to order further testing to identify the cause. Because inflammation is minimal, however, a finding of diminished levels of the liver’s synthetic products, such as albumin, may be more helpful. If hereditary hemochromatosis is among the disorders being considered to explain organ dysfunction, serum iron, transferrin saturation, and serum ferritin testing are warranted because elevations in these values are among the earliest findings in most forms of hemochromatosis. Genetic testing for known mutations provides confirmation of the diagnosis for most patients with hereditary hemochromatosis. It is especially valuable for testing nonaffected family members who can be counseled in lifestyle changes to prevent the phenotype from developing or for whom early treatment interventions can prevent organ damage.
Whether hemochromatosis is acquired or hereditary, the serum ferritin level provides an assessment of the degree of iron overload and can be monitored after treatment is initiated to reduce iron stores. Hemoglobin concentration and hematocrit are inexpensive tests that can also be used to monitor treatment, as described later.
Determination of the actual extent of tissue damage is beyond the scope of the clinical laboratory. Liver biopsy with assessment of iron staining and degree of scarring in liver specimens is essential to determining the degree of organ damage.
Treatment
The treatment of secondary tissue damage, such as liver cirrhosis and heart failure, follows standard protocols. Treatment of the underlying condition leading to excess iron accumulation is also needed. Hereditary hemochromatosis and transfusion-related hemosiderosis require different treatment approaches. In forms of hereditary hemochromatosis, withdrawal of blood by phlebotomy provides a simple, inexpensive, and effective means of removing iron from the body. The regimen calls for weekly phlebotomy early in treatment to remove about 500 mL of blood per treatment. Maintenance phlebotomies are required about every 3 months for life.56 Hemoglobin levels are monitored, and a mild anemia is sought and maintained. Such monitoring is an easy and inexpensive substitute for iron studies because, as explained in the discussion of iron deficiency, iron stores must be exhausted before anemia develops.
Individuals who rely on transfusions to maintain hemoglobin levels and prevent anemia cannot be treated with phlebotomy. Instead, iron-chelating drugs are used to bind excess iron in the body for excretion. Desferrioxamine is the classic treatment, although it is not without side effects.57 The drug typically is injected subcutaneously to maximize exposure time for iron binding. When absorbed into the bloodstream with its bound iron, it is readily excreted in the urine. Recently, oral iron chelators have been developed.58, 59 Although they also have side effects, the convenience of oral administration with the potential for improved patient outcomes may lead to a greater reliance on this form of treatment.
Summary
• Impaired iron kinetics or heme metabolism can result in microcytic, hypochromic anemias.
• Three conditions affecting iron kinetics can result in microcytic, hypochromic anemias: iron deficiency, anemia of chronic inflammation, and sideroblastic anemias, especially lead poisoning. The RBCs in thalassemias also may be microcytic and hypochromic, and this condition must be differentiated from the anemias of disordered iron metabolism.
• Iron deficiency results from inadequate iron intake, increased need, decreased absorption, or excessive loss. All four of these situations create a relative deficit of body iron that over time results in a microcytic, hypochromic anemia.
• Infants, children, and women of childbearing age are at greatest risk for iron deficiency anemia. If iron deficiency anemia is present in men and postmenopausal women, the possibility of gastrointestinal bleeding should be investigated because it is the primary, although not the only, cause of iron loss.
• Iron deficiency is suspected when the CBC shows microcytic, hypochromic RBCs and elevated RDW but no consistent morphologic abnormality. The diagnosis is confirmed with iron studies showing low levels of serum iron and serum ferritin, elevated TIBC, and decreased transferrin saturation.
• Inadequate dietary iron is treated by oral supplementation, and with good patient adherence, the anemia should be corrected within 3 months. Gastrointestinal distress resulting from iron supplements can make patient adherence a significant concern. Other causes of iron deficiency must be treated by eliminating the underlying cause or with intravascular iron administration.
• The anemia of chronic inflammation (ACI) is associated with chronic infections such as tuberculosis, chronic inflammatory conditions such as rheumatoid arthritis, and tumors. It may be a microcytic, hypochromic anemia, but most often it is a mild normocytic, normochromic anemia.
• In ACI, increased levels of hepcidin, an acute phase reactant, decrease iron absorption in the intestines and sequester iron in macrophages and hepatocytes. Bone marrow macrophages show abundant stainable iron, whereas developing RBCs show inadequate iron. Inflammatory cellular products also impair the production and action of erythropoietin.
• Iron studies in the anemia of chronic inflammation show decreased serum iron level, decreased TIBC, decreased or normal transferrin saturation, and normal or increased ferritin level.
• Sideroblastic anemias develop when the synthesis of protoporphyrin or the incorporation of iron into protoporphyrin is blocked. The result is accumulation of iron in the mitochondria of developing RBCs. When stained using Prussian blue, the iron appears in deposits around the nucleus of the developing cells in the bone marrow. These cells are called ring sideroblasts.
• Protoporphyrin synthesis and iron incorporation into protoporphyrin can be blocked when any of the enzymes of the heme synthetic pathway are deficient or impaired. Deficiencies of these enzymes may be hereditary, as in the porphyrias, or acquired, as in heavy metal poisoning. The most common of the latter conditions is lead poisoning.
• Iron studies in sideroblastic anemias show elevated levels of serum iron and serum ferritin, decreased or normal TIBC, and increased transferrin saturation. Test values for the accumulating products of the heme synthetic pathway, such as zinc protoporphyrin (ZPP) or free erythrocyte protoporphyrin (FEP), are also elevated.
• Lead interferes with several steps in heme synthesis, preventing iron incorporation into heme and resulting in a normocytic, normochromic anemia, although with long-term exposure it can be microcytic and hypochromic. Lead also impairs glucose-6-phosphate dehydrogenase, which adds a hemolytic component to the anemia.
• Children are especially vulnerable to the effects of lead on the central nervous system, which may result in irreversible brain damage. Treatment consists of removing the source of lead from the patient’s environment and, if necessary, chelating drug therapy to facilitate excretion of lead in the urine.
• Because the body has no mechanism for iron excretion, iron overload can occur when transfusions are used to sustain patients with chronic anemias such as β-thalassemia major (called transfusion-related hemosiderosis).
• A defective HFE gene can lead to hereditary hemochromatosis by decreased hepcidin production. Affected men develop symptoms earlier in life than women; homozygotes develop more severe disease than heterozygotes.
• Mutations of other genes affecting iron regulation can produce a phenotype similar to that of hereditary hemochromatosis. When the hepcidin or hemojuvelin gene is mutated, the disease develops early in life, affecting even teenagers.
• Free iron becomes available in cells when ferritin and hemosiderin become saturated. Free iron causes tissue damage by creating free radicals that lead to cell membrane damage and perhaps mutations. The liver, pancreas, skin, and heart muscle are especially damaged by excess iron deposition.
• Elevated transferrin saturation can be an indicator of hemochromatosis that can be diagnosed fully using genetic testing to identify mutated genes.
• Hereditary hemochromatosis and similar diseases are treated by lifelong periodic phlebotomy to induce a mild iron deficiency anemia and keep body iron levels low. Transfusion-related hemosiderosis must be treated with iron-chelating drugs.
Now that you have completed this chapter, go back and read again the case study at the beginning and respond to the questions presented.
Review questions
Answers can be found in the Appendix.
1. The mother of a 4-month-old infant who is being breastfed sees her physician for a routine postpartum visit. She expresses concern that she may be experiencing postpartum depression because she does not seem to have any energy. Although the physician is sympathetic to the patient’s concern, she orders a CBC and iron studies seeking an organic explanation for the patient’s symptoms. The results are as follows:
CBC: all results within reference intervals except
RDW = 15%
Serum iron: decreased
TIBC: increased
% transferrin saturation: decreased
Serum ferritin: decreased
Correlate the patient’s laboratory and clinical findings. What can you conclude?
a. The results of the iron studies reveal findings consistent with a thalassemia that was apparently previously undiagnosed.
b. The patient is in stage 2 of iron deficiency, before frank anemia develops.
c. The results of the iron studies are inconsistent with the CBC results, and a laboratory error should be suspected.
d. There is no evidence of a hematologic explanation for the patient’s symptoms.
2. A bone marrow biopsy was performed as part of the cancer staging protocol for a patient with Hodgkin lymphoma. Although no evidence of spread of the tumor was apparent in the marrow, other abnormal findings were noted, including a slightly elevated myeloid-to-erythroid ratio. WBC and RBC morphology appeared normal, however. The Prussian blue stain showed abundant stainable iron in the marrow macrophages. The patient’s CBC revealed a hemoglobin of 10.8 g/dL, but RBC indices were within reference intervals. RBC morphology was unremarkable. These findings would be consistent with:
a. Anemia of chronic inflammation
b. Sideroblastic anemia
c. Thalassemia
d. Iron deficiency anemia
3. Predict the iron study results for the patient with Hodgkin lymphoma described in question 2.
|
Serum Iron Level |
TIBC |
% Transferrin Saturation |
Serum Ferritin Level |
|
|
a. |
Decreased |
Increased |
Decreased |
Decreased |
|
b. |
Increased |
Normal |
Increased |
Normal |
|
c. |
Increased |
Increased |
Normal |
Increased |
|
d. |
Decreased |
Decreased |
Normal |
Normal |
4. A 35-year-old white woman went to her physician complaining of headaches, dizziness, and nausea. The headaches had been increasing in severity over the past 6 months. This was coincident with her move into an older house built about 1900. She had been renovating the house, including stripping paint from the woodwork. Her CBC results showed a mild hypochromic, microcytic anemia, with polychromasia and basophilic stippling noted. Which of the following tests would be most useful in confirming the cause of her anemia?
a. Serum lead level
b. Serum iron level and TIBC
c. Absolute reticulocyte count
d. Prussian blue staining of the bone marrow to detect iron stores in macrophages
5. In men and postmenopausal women whose diets are adequate, iron deficiency anemia most often results from:
a. Increased need associated with aging
b. Impaired absorption in the gastric mucosa
c. Chronic gastrointestinal bleeding
d. Diminished resistance to hookworm infections
6. Which one of the following individuals is at greatest risk for the development of iron deficiency anemia?
a. A 15-year-old boy who eats mainly fast food and junk food
b. A 37-year-old woman who has never been pregnant and has amenorrhea
c. A 63-year-old man with reactivation of tuberculosis from his childhood
d. A 40-year-old man who lost blood during surgery to repair a fractured leg
7. Which of the following individuals is at the greatest risk for the development of anemia of chronic inflammation?
a. A 15-year-old girl with asthma
b. A 40-year-old woman with type 2 diabetes mellitus
c. A 65-year-old man with hypertension
d. A 30-year-old man with severe rheumatoid arthritis
8. In what situation will increased levels of free erythrocyte protoporphyrin be present?
a. Gain of function mutation to one of the enzymes in the heme synthesis pathway
b. A mutation that prevents heme attachment to globin so that protoporphyrin remains free
c. Any condition that prevents iron incorporation into protoporphyrin IX
d. When red blood cells lyse, freeing their contents into the plasma
9. In the pathogenesis of the anemia of chronic inflammation, hepcidin levels:
a. Decrease during inflammation and reduce iron absorption from enterocytes
b. Increase during inflammation and reduce iron absorption from enterocytes
c. Increase during inflammation and increase iron absorption from enterocytes
d. Decrease during inflammation and increase iron absorption from enterocytes
10. Sideroblastic anemias result from:
a. Sequestration of iron in hepatocytes
b. Inability to incorporate heme into apohemoglobin
c. Sequestration of iron in myeloblasts
d. Failure to incorporate iron into protoporphyrin IX
11. In general, the hereditary hemochromatoses result from mutations that impair:
a. The manner in which developing red cells acquire and manage iron
b. The hepcidin-ferroportin iron regulatory system
c. The TfR-Tf endocytic iron acquisition process for body cells other than blood cells
d. The function of divalent metal transporter in enterocytes and macrophages
12. In the erythropoietic porphyrias, mild anemia may be accompanied by what distinctive clinical finding?
a. Gallstones
b. Impaired night vision
c. Unintentional nighttime leg movements
d. Heightened propensity for sunburn
Also review Chapter 11, questions 4 and 12 to 14 pertinent to the diagnostic value of various tests of iron status.
References
1. Hallberg L. Bioavailability of dietary iron in man. Annu Rev Nutr; 1981; 1:123-147.
2. Silvestri L, Guillem F, Pagani A, et al. Molecular mechanisms of the defective hepcidin inhibition in TMPRSS6 mutations associated with iron-refractory iron deficiency anemia. Blood; 2009; 113(22):5605-5608.
3. Suominen P, Punnonen K, Rajamaki A, et al. Serum transferrin receptor and transferrin receptor–ferritin index identify healthy subjects with subclinical iron deficits. Blood; 1998; 92:2934-2939.
4. Cogswell M. E, Looker A. C, Pfeiffer C. M, et al. Assessment of iron deficiency in US preschool children and nonpregnant females of childbearing age National Health and Nutrition Examination Survey 2003-2006. Am J Clin Nutr; 2009; 89:1334-1342.
5. Goodnough L. T, Nemeth E. Iron deficiency and related disorders. Chapter 23 In: Greer J. P, Arber D. A, Glader D, List A. F, Means R. T, Paraskevas F, Rodgers G. M, Foerster J. Wintrobe’s Clinical Hematology. 13th ed. Philadelphia : Lippincott Williams & Wilkins 2014 Accessed 03.01.14.
6. Green R, Charlton R, Seftel H, et al. Body iron excretion in man a collaborative study. Am J Med; 1968; 45:336-353.
7. Saarinen U. M, Siimes A, Dallman P. R. Iron absorption in infants high bioavailability of breast milk iron as indicated by the extrinsic tag method of iron absorption and by the concentration of serum ferritin. J Pediatr; 1977; 91:36-39.
8. Siimes M. A, Vuori E, Kuitunen P. Breast milk iron a declining concentration during the course of lactation. Acta Paediatr Scand; 1979; 68:29-31.
9. Yoshimura H. Anemia during physical training (sports anemia). Nutri Rev; 1970; 28:251-276.
10. Thompson W. G, Meola T, Lipkin M, Jr, et al. Red cell distribution width, mean corpuscular volume, and transferrin saturation in the diagnosis of iron deficiency. Arch Intern Med; 1988; 148:2128-2130.
11. McClure S, Custer E, Bessman J. D. Improved detection of early iron deficiency in nonanemic subjects. JAMA; 1985; 253:1021-1023.
12. Charlton R. W, Bothwell T. H. Definition, prevalence and prevention of iron deficiency. Clin Haematol; 1982; 11:309-325.
13. Cox L. A, Adrian G. S. Postransciptional regulation of chimeric human transferrin genes by iron. Biochemistry; 1993; 32:4738-4745.
14. Brugnara C, Schiller B, Moran J. Reticulocyte hemoglobin equivalent (Ret He) and assessment of iron deficient states. Clin Lab Haem; 2006; 29:303-306.
15. Lamola A. A, Joselow M, Yamane T. Zinc protoporphyrin (ZPP) a simple, sensitive fluorometric screening test for lead poisoning. Clin Chem; 1975; 21:93-97.
16. Huebers H. A, Beguin Y, Pootrakul P, et al. Intact transferrin receptors in human plasma and their relation to erythropoiesis. Blood; 1990; 75:102-107.
17. O’Sullivan D. J, Higgins P. G, Wilkinson J. F. Oral iron compounds a therapeutic comparison. Lancet; 1955; 2:482-485.
18. Swan H. T, Jowett G. H. Treatment of iron deficiency with ferrous fumarate assessment by a statistically accurate method. BMJ; 1959; 2:782-787.
19. Cartwright G. E. The anemia of chronic disorders. Semin Hematol; 1966; 3:351-375.
20. Sears D. A. Anemia of chronic disease. Med Clin North Am; 1992; 76:567-579.
21. Nemeth E, Tuttle M. S, Powelson J, et al. Hepcidin regulates iron efflux by binding to ferroportin and inducing its internalization. Science; 2004; 306:2090-2093.
22. Rivera S, Liu L, Nemeth E, et al. Hepcidin excess induces the sequestration of iron and exacerbates tumor-associated anemia. Blood; 2005; 105:1797-1802.
23. Nicolas G, Bennoun M, Devaux I, et al. Lack of hepcidin gene expression and severe tissue iron overload in upstream stimulatory factor 2 (USF2) knockout mice. Proc Natl Acad Sci U S A; 2001; 98:8780-8785.
24. Nicolas G, Chauvet C, Viatte L, et al. The gene encoding the iron regulatory peptide hepcidin is regulated by anemia, hypoxia, and inflammation. J Clin Invest; 2002; 110:1037-1044.
25. Masson P. L, Heremans J. F, Schonne E. Lactoferrin an iron binding protein in neutrophilic leukocytes. J Exp Med; 1969; 130:643-658.
26. Ganz T. Hepcidin, a key regulator of iron metabolism and mediator of anemia in inflammation. Blood; 2003; 102:783-788.
27. Weiss G, Goodnough L. T. Anemia of chronic disease. N Engl J Med; 2005; 352:1011-1023.
28. Means R. T. Anemias secondary to chronic disease and systemic disorders. Chapter 41 In: Greer J. P, Arber D. A, Glader D, List A. F, Means R. T, Paraskevas F, Rodgers G. M, Foerster J. Wintrobe’s Clinical Hematology.13th ed. Philadelphia : Lippincott Williams & Wilkins 2014 Accessed 03.01.14.
29. Castel R, Tax M. G, Droogendijk J, et al. The transferrin/log(ferritin) ratio a new tool for the diagnosis of iron deficiency anemia. Clin Chem Lab Med; 2012; 50:1343-1349.
30. Mast A. E, Blinder M. A, Gronowski A. M, et al. Clinical utility of the soluble transferrin receptor and comparison with serum ferritin in several populations. Clin Chem; 1998; 44:45-51.
31. Thomas C, Thomas L. Biochemical markers and hematologic indices in the diagnosis of functional iron deficiency. Clin Chem; 2002; 48:1066-1076.
32. Leers M.P.G, Keuren J. F.W, Oosterhuis W.P. The value of the Thomas-plot in the diagnostic work up of anemic patients referred by general practitioners. Int J Lab Hemat; 2010; 32:572-581.
33. Pincus T, Olsen N. J, Russell I. J, et al. Multicenter study of recombinant human erythropoietin in correction of anemia in rheumatoid arthritis. Am J Med; 1990; 89:161-168.
34. Arndt U, Kaltwasser J. P, Gottschalk R, et al. Correction of iron-deficient erythropoiesis in the treatment of anemia of chronic disease with recombinant human erythropoietin. Ann Hematol; 2005; 84:159-166.
35. Horrigan D. L, Harris J. W. Pyridoxine responsive anemia analysis of 62 cases. Adv Intern Med; 1964; 12:103-174.
36. Verwilghen R, Reybrouck G, Callens L, et al. Antituberculosis drugs and sideroblastic anemia. Br J Haematol; 1965; 11:92-98.
37. Benson P. Lead poisoning in children. Dev Med Child Neurol; 1965; 7:569-571.
38. Campbell A. M, Williams E. R. Chronic lead intoxication mimicking motor neurone disease. BMJ; 1968; 4:582.
39. Granick S, Sassa S, Granick J. L, et al. Assays for porphyrins, delta-aminolevulinic acid dehydratase, and porphyrinogen synthetase in microliter samples of blood application to metabolic defects involving the heme pathway. Proc Natl Acad Sci U S A; 1972; 69:2381-2385.
40. Lachant N.A, Tomoda A, Tanaka K.R, et al. Inhibition of the pentose phosphate shunt by lead a potential mechanism for hemolysis in lead poisoning. Blood; 1984; 63:518-524.
41. Bottomley S. S. Sideroblastic anemias. Chapter 24 In: Greer J.P, Arber D.A, Glader D, List A.F, Means R.T, Paraskevas F, Rodgers G.M, Foerster J. Wintrobe’s Clinical Hematology. 13th ed. Philadelphia : Lippincott Williams & Wilkins 2014 Accessed 03.01.14.
42. Valentine W. N, Paglia D. E, Fink K, et al. Lead poisoning. Association with hemolytic anemia, basophilic stippling, erythrocyte pyrimidine 5’-nucleotidase deficiency, and intraerythrocytic accumulation of pyrimidines. J Clin Invest; 1976; 58:926-932.
43. Feder J. N, Gnirke A, Thomas W, et al. A novel MHC class I-like gene is mutated in patients with hereditary haemochromatosis. Nat Genet; 1996; 13:399-408.
44. Waheed A, Parkkila S, Zhou X. Y, et al. Hereditary hemochromatosis effect of C282Y and H63D mutations on association with b2-microglobulin, intracellular processing, and cell surface expression of the HFE protein in COS-7 cells. Proc Natl Acad Sci U S A; 1997; 94:12384-12389.
45. Brissot P, Bardou-Jacquet E, Troadec M. B, et al. Molecular diagnosis of genetic iron-overload disorders. Expert Rev Mol Diagn; 2010; 10:755-763.
46. Beutler E. The HFE Cys282Tyr mutation as a necessary but not sufficient cause of clinical hereditary hemochromatosis. Blood; 2003; 101:3347-3350.
47. Lebron J. A, Bjorkman P. J. The transferrin receptor binding site on HFE, the class I MHC-related protein mutated in hereditary hemochromatosis. J Mol Biol; 1999; 289:1109-1118.
48. McCord J. M. Iron, free radicals, and oxidative injury. Semin Hematol; 1998; 35:5-12.
49. Vautier G, Bomford A. B, Portmann B. C, et al. p53 mutations in British patients with hepatocellular carcinoma clustering in genetic hemochromatosis. Gastroenterology; 1999; 117:154-160.
50. Hussain S. P, Raja K, Amstad P. A, et al. Increased p53 mutation load in nontumorous human liver of Wilson disease and hemochromatosis oxyradical overload diseases. Proc Natl Acad Sci U S A; 2000; 97:12770-12775.
51. Niederau C, Strohmeyer G, Stremmel W. Long term survival in patients with hereditary hemochromatosis. Gastroenterology; 1996; 110:1107-1119.
52. Bothwell T. H, MacPhail A. P. Hereditary hemochromatosis etiologic, pathologic, and clinical aspects. Semin Hematol; 1998; 35:55-71.
53. Nadakkavukaran I. M, Gan E. K, Olynyk J. K. Screening for hereditary haemochromatosis. Pathology; 2012; 44:148-152.
54. Phatak P. D, Guzman G, Woll J. E, et al. Cost effectiveness of screening for hemochromatosis. Arch Intern Med; 1994; 154:769-776.
55. Rogowski W. H. The cost-effectiveness of screening for hereditary hemochromatosis in Germany a remodeling study. Med Decis Making; 2009; 29:224-238.
56. Edwards C. Q, Barton J. C. Hemochromatosis. Chapter 25 In: Greer J. P, Arber D. A, Glader D, List A. F, Means R. T, Paraskevas F, Rodgers G. M, Foerster J. Wintrobe’s Clinical Hematology. 13th ed. Philadelphia : Lippincott Williams & Wilkins 2014 Accessed 3.01.14.
57. Borgna-Pignatti C, Galanello R. Thalassemias and related disorders Quantitative disorders of hemoglobin synthesis. In: Greer J. P, Arber D. A, Glader D, List A. F, Means R. T, Paraskevas F, Rodgers G. M, Foerster J. Wintrobe’s Clinical Hematology. 13th ed. Philadelphia : Lippincott Williams & Wilkins 2014 Accessed 03.01.14.
58. Cappellini M. D, Pattoneri P. Oral iron chelators. Annu Rev Med; 2009; 60:25-38.
59. Imran F, Phatak P. Pharmacoeconomic benefits of deferasirox in the management of iron overload syndromes. Expert Rev Pharmacoecon Outcomes Res; 2009; 9:297-304.